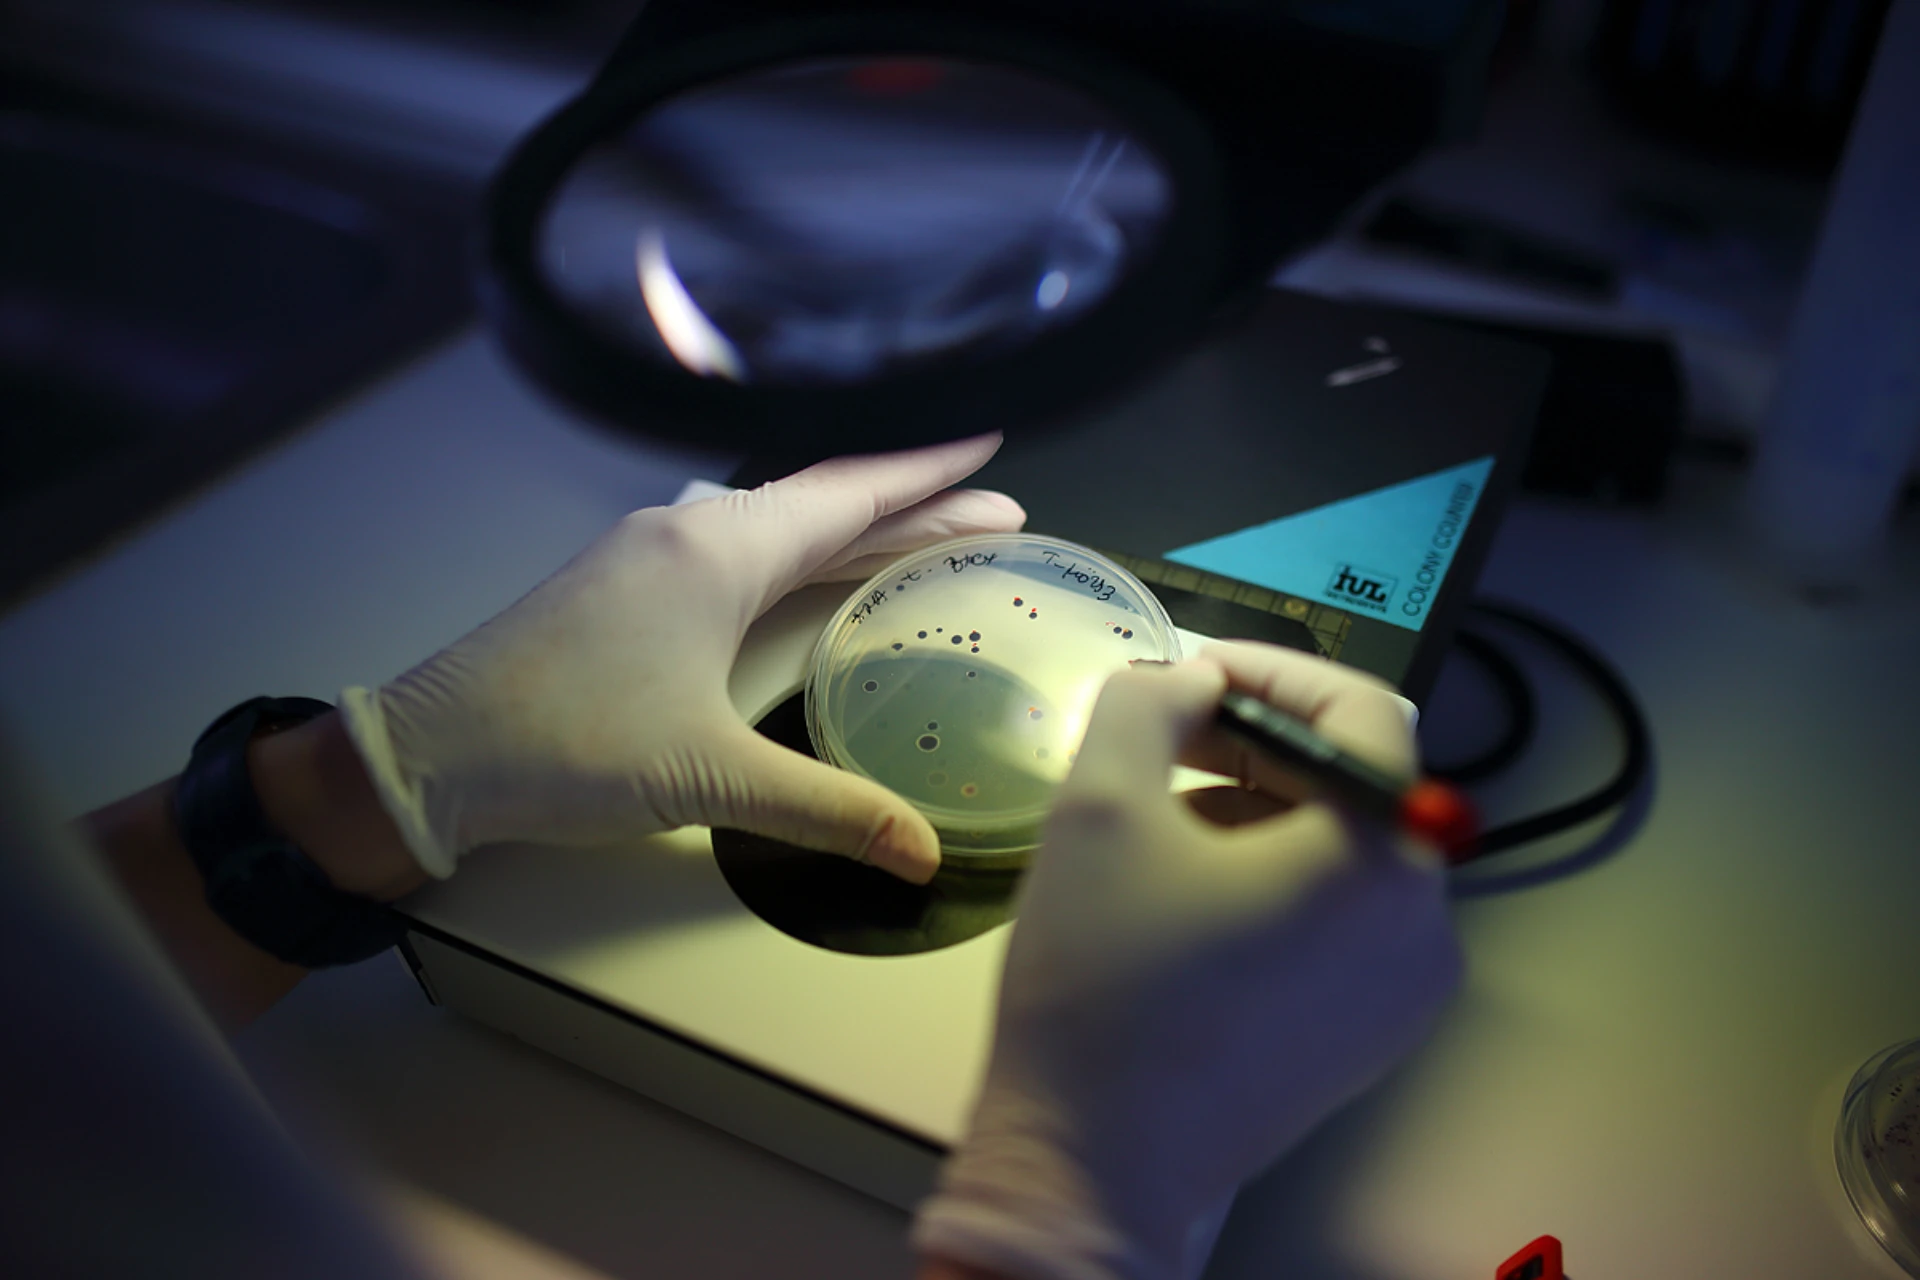

Waste
Improving the efficiency of biogas plants: innovative solutions to industrial challenges
Biogas plants are a sustainable energy source, but their operation poses a number of technological and environmental challenges. Our institute offers practical solutions for increasing fermentation yields, stabilising gas yields and optimising sludge treatment – for more efficient and profitable operation.

Bioremediation
Bioremediation is the decontamination of soils and water using living microorganisms, mainly bacteria, and offers an effective, chemical-free and environmentally friendly solution for soil and water treatment. Our targeted biological systems can also be used in combination with physico-chemical processes to degrade organic contaminants, helping to restore the environment and prevent further damage.
Industrial solutions for battery recycling – biotechnology and chemistry
The global and domestic battery boom is key to the future of electromobility and energy storage. Hungary is aiming to become a centre of the European battery industry, but as production rises, there is a growing need for environmentally sound and economical recycling of spent batteries and waste streams from inter-production (Regulation (EU) 2023/1542 of the European Parliament and of the Council).


Geospatial analysis, machine vision surveys and (time-series) analysis to support environmental and remediation processes
Their geospatial analyses support environmental assessment and remediation processes, building on drone data collection and machine vision-assisted time-series evaluations. The method can be used to continuously monitor and document the environmental impacts of mining sites, solar power plants and other industrial facilities.
Environmental Technologies
In the field of Environmental Technologies, our institute develops unique, cost-effective biotechnological and chemical systems for which the market does not offer ready-made solutions. With our automated, remotely accessible tools and prototypes, we efficiently support our partners' laboratory and field processes – from design to implementation.


Leaching/Bioleaching
By developing and optimising bioleaching technology, our institute offers an environmentally friendly solution for the recycling of metal-containing waste. By combining sulphur-oxidising bacteria and hydrometallurgical methods, we help our partners to increase the efficiency of metal recovery from secondary raw materials – from design to industrial implementation.
Recovery of secondary raw materials with adsorbents
Removing heavy metals from water is a major environmental challenge, and our institute offers an efficient and sustainable solution with adsorbents made from secondary raw materials. By testing the performance, regenerability and industrial applicability of adsorption systems, we develop targeted technologies for our partners to support the circular economy.
